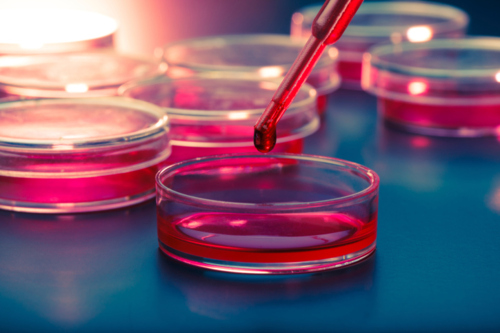
•Pruebas químicas en general 
•Cultivo general 
•Urinálisis 
•Pruebas de embarazo 
•CBC en Minutos 
•Pruebas de Dopaje 
•Pruebas de Coagulación

Address
- Carr. #633 Km. 4.9 Bo. Barahona, Morovis, Puerto Rico 00687
Phone
Business hours
Brands
- • We accept the majority of healthcare coverages including "Mi Salud"
Products or Services
-
• Chemical Test Overview
• General Growing
• Urinalysis
• Pregnancy testing
• CBC in Minutes
• Doping Tests
• Coagulation Tests
Payment methods
ATH
Credit Card
Cash
Established over 6 years ago. We have the most modern and sophisticated equipment for processing laboratory samples.
- Professionalism -Service -Fast The Torremar Clinical Laboratory opened its doors to provide services to the residents of the town of Morovis.
With the grace of God we have the most advanced and sophisticated equipment for processing laboratory samples. We have the most modern and sophisticated equipment for processing laboratory samples. To provide you with quality results.